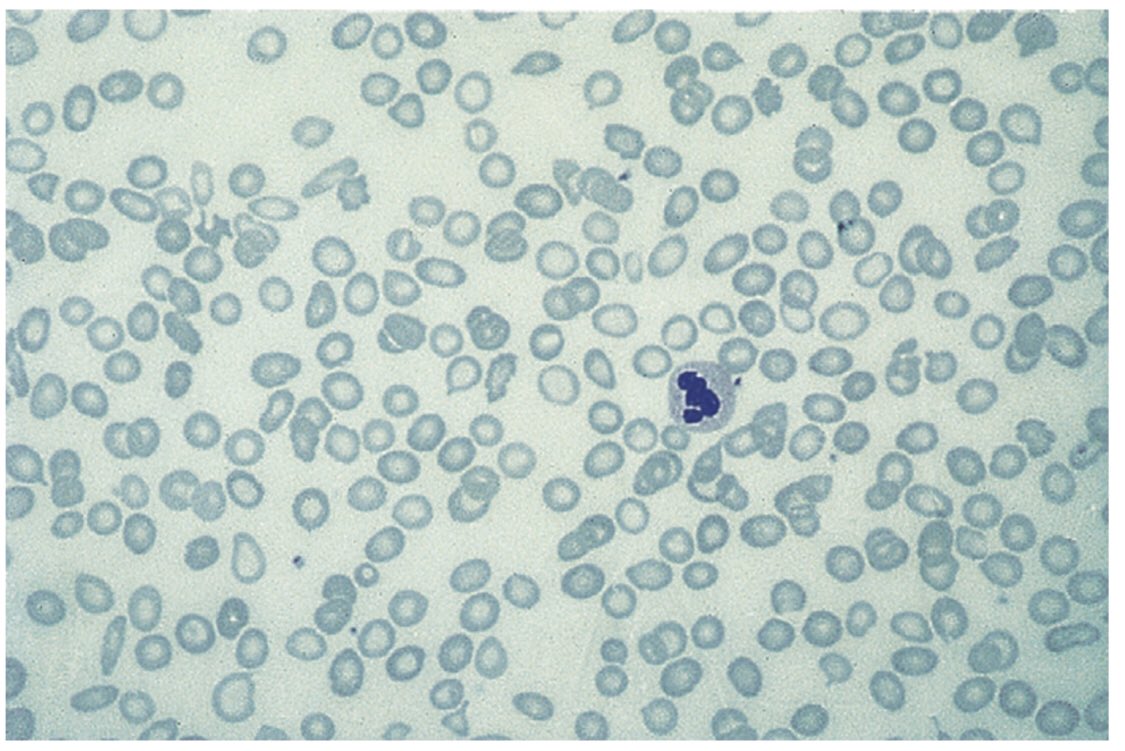

وعندما يفتقر الجسم إلى كمية كافية من الحديد، فإنه لا يستطيع أن ينتج ما يكفي من مادة خلايا الدم الحمراء التي تمكنها من نقل الأكسجين مما يؤدي إلى حدوث فقر الدم
وربما يكون انخفاض كمية الحديد بالجسم لأسباب أخرى مثل
▫️نزول دم بكميات كبيرة أثناء الدورة الشهرية بصفة مستمرة
وربما يكون انخفاض كمية الحديد بالجسم لأسباب أخرى مثل
▫️نزول دم بكميات كبيرة أثناء الدورة الشهرية بصفة مستمرة
▫️فقدان الدم من الجهاز الهضمي بسبب تقرحات الجهاز الهضمي والاستخدام المستمر لبعض الأدوية مثل: الإسبرين والايبوبروفين
▫️بعد إجراء العمليات الجراحية
▫️التبرع المستمر وغير المنتظم بالدم
▫️تناول كميات حديد أقل من احتياج الجسم اليومي وربما يحدث ذلك عند اتباع عادات غذائية خاطئة،
▫️بعد إجراء العمليات الجراحية
▫️التبرع المستمر وغير المنتظم بالدم
▫️تناول كميات حديد أقل من احتياج الجسم اليومي وربما يحدث ذلك عند اتباع عادات غذائية خاطئة،
مثل اتباع حمية غذائية نباتية؛ لأن الحديد يوجد بنسب كبيرة في اللحوم والأسماك
▫️وجود مشكلة في امتصاص الحديد في الجسم بسبب بعض مشكلات الأمعاء، والهضم، مثل: مرض السيلياك، والتهابات القولون المزمنة، وعدوى بكتيريا الهليكوباكتر بيلوري
▫️أمراض الكلى في مراحلها المتقدمة
▫️وجود مشكلة في امتصاص الحديد في الجسم بسبب بعض مشكلات الأمعاء، والهضم، مثل: مرض السيلياك، والتهابات القولون المزمنة، وعدوى بكتيريا الهليكوباكتر بيلوري
▫️أمراض الكلى في مراحلها المتقدمة
الأعراض
▪️حدوث آلام في الصدر
▪️الشعور بالتعب والإرهاق الشديد
▪️برودة اليدين والقدمين
▪️صعوبة في التركيز
▪️الصداع والدوخة وشحوب الجلد
▪️عدم انتظام نبضات القلب
▪️الرغبة الشديدة في تناول المواد غير الغذائية مثل: الثلج أو الطلاء أو الطين
▪️ضيق في النفس
▪️حدوث آلام في الصدر
▪️الشعور بالتعب والإرهاق الشديد
▪️برودة اليدين والقدمين
▪️صعوبة في التركيز
▪️الصداع والدوخة وشحوب الجلد
▪️عدم انتظام نبضات القلب
▪️الرغبة الشديدة في تناول المواد غير الغذائية مثل: الثلج أو الطلاء أو الطين
▪️ضيق في النفس
▪️سهولة تكسر الأظافر، وتغير شكلها، إذ تصبح مثل: الملعقة
▪️تشققات حول الفم
▪️تورم اللسان، وتقرحه
المضاعفات:
🔺زيادة فرص حدوث عدوى متكررة
🔺مشكلات بالقلب لأن القلب يبذل مجهودًا مضاعفًا لضخ الدم إلى خلايا الجسم لتعويض نقص الأكسجين في الدم. ويمكن أن يؤدي ذلك إلى تضخم القلب، أو فشله
▪️تشققات حول الفم
▪️تورم اللسان، وتقرحه
المضاعفات:
🔺زيادة فرص حدوث عدوى متكررة
🔺مشكلات بالقلب لأن القلب يبذل مجهودًا مضاعفًا لضخ الدم إلى خلايا الجسم لتعويض نقص الأكسجين في الدم. ويمكن أن يؤدي ذلك إلى تضخم القلب، أو فشله
أو عدم انتظام نبضاته
🔺في حالة المرأة الحامل، قد يؤدي إلى ولادة مبكرة، أو ولادة طفل ناقص الوزن
العلاج:
✔️مكملات الحديد:
توصف هذه المكملات في حالة نقص تناول الحديد بما يواكب احتياج الجسم ✔️تغيير العادات الغذائية، مثل: التقليل من شرب الشاي لأنه يعيق امتصاص الحديد
🔺في حالة المرأة الحامل، قد يؤدي إلى ولادة مبكرة، أو ولادة طفل ناقص الوزن
العلاج:
✔️مكملات الحديد:
توصف هذه المكملات في حالة نقص تناول الحديد بما يواكب احتياج الجسم ✔️تغيير العادات الغذائية، مثل: التقليل من شرب الشاي لأنه يعيق امتصاص الحديد
كما يجب زيادة كمية فيتامين سي مع تناول الحديد؛ لأنه يساعد على امتصاصه
✔️و اذا كان السبب هو فقد الدم لسبب غير الحيض، فلا بد من تحديد مصدر النزيف، وإيقافه، وقد يلزم إجراء جراحة
الأطعمة الغنية بالحديد
اللحوم، والأسماك، والفواكه، مثل الرمان، والخضراوات، مثل السبانخ، والبنجر
✔️و اذا كان السبب هو فقد الدم لسبب غير الحيض، فلا بد من تحديد مصدر النزيف، وإيقافه، وقد يلزم إجراء جراحة
الأطعمة الغنية بالحديد
اللحوم، والأسماك، والفواكه، مثل الرمان، والخضراوات، مثل السبانخ، والبنجر
جاري تحميل الاقتراحات...